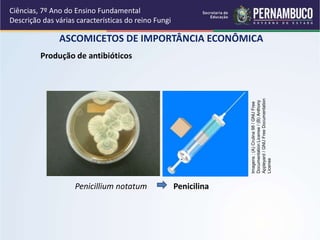
ASCOMICETOS DE IMPORTÂNCIA ECONÔMICA
Ciências, 7º Ano do Ensino Fundamental
Descrição das várias características do reino Fungi
Produção de antibióticos
Penicillium notatum Penicilina
Imagens:(A)Crulina98/GNUFree
DocumentationLicense/(B)Anthony
Appleyard/GNUFreeDocumentation
License

O documento descreve as características do reino Fungi, incluindo que eles são eucariontes, heterotróficos, aeróbios ou anaeróbios, e se reproduzem assexuada ou sexualmente. Muitos fungos são economicamente importantes, produzindo alimentos, antibióticos e outras substâncias. Alguns fungos formam associações simbióticas com plantas e algas.